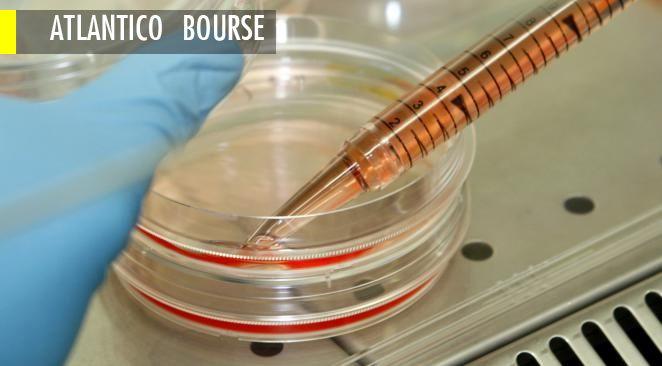
Article cover

Contenus en rapport avec le mot-cle
"BIOTECHNOLOGIES"
REVES D'ETERNITE
Greffes, biotechnologie et vie éternelle : les confidences improbables de Poutine et Xi2 min de lecture
"LA POSSIBILITE D'UNE ILE"
SANTE OBLIGE
BIOTECHNOLOGIES VEGETALES
Quel avenir pour une société qui confond science et opinion ?
1 min de lecture
BRAVE NEW WORLD ?
ATLANTICO BOURSE
TALENTS TRICOLORES
BONNES FEUILLES
Plus de résultats disponibles